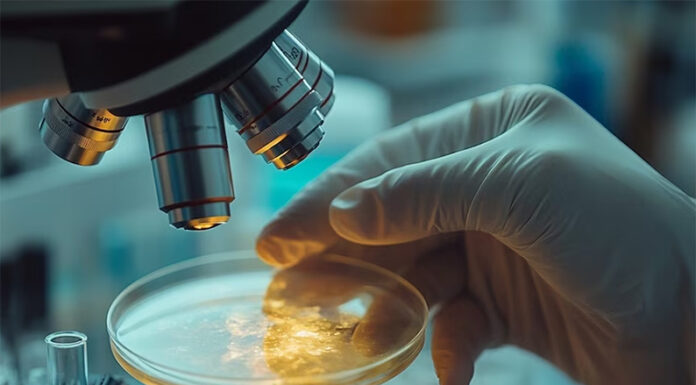
De la exploración espacial a la IA: los hitos científicos y tecnológicos que definirán el 2026, según Nature

Etiqueta: IA
Tecnología
Elon Musk advierte el fin de una profesión: “para finales de 2026 ni siquiera habrá que preocuparse por ella”
Redactor EL DEBATE - 0
El empresario considera que la IA ya permite automatizar gran parte del trabajo de los desarrolladores
Elon Musk ha lanzado una advertencia a los programadores, asegurando...
Internacionales
De la exploración espacial a la IA: los hitos científicos y tecnológicos que definirán el 2026, según Nature
Redactor EL DEBATE - 0
Experimentos inéditos en laboratorios, ensayos médicos a gran escala y ambiciosas misiones interplanetarias marcarán la agenda del próximo año. El repaso de la icónica...
Tecnología
Emprendedores argentinos crearon una solución de IA para hoteles que se extendió a 20 países en sólo dos años
Redactor EL DEBATE - 0
La startup WeSpeak desarrolló una herramienta conversacional para gestionar con mayor eficiencia las reservas a través de Whatsapp. Empezaron trabajando para campings en el...
Provinciales
¿Cuánto sabemos sobre IA?: lanzan una encuesta para medir el impacto de la inteligencia artificial
Redactor EL DEBATE - 0
El cuestionario, preparado por la Defensoría del Pueblo bonaerense, servirá para “poner en cifras” el fenómeno de la IA.
Cuál es la inteligencia artificial (IA) más usada,...
Un sondeo de la UdeSA reveló que el 25% de la Generación Z se siente más entusiasmada que preocupada por la inteligencia artificial, mientras...
Salud
Expertos en neurociencia y salud mental advirtieron que la IA podría dañar el cerebro de los niños más que las redes sociales
Redactor EL DEBATE - 0
Especialistas alertan que el uso constante de asistentes de inteligencia artificial podría afectar la memoria, aumentar la ansiedad y debilitar habilidades cognitivas fundamentales en...
Durante el viaje, los argentinos la utilizan para traducir (47%), buscar actividades en el lugar (48%) y para poder trasladarse (43%).
Booking.com publicó el Informe...
Tecnología
“Saquen una hoja”: por el uso de la IA, cada vez más docentes vuelven al examen escrito
Redactor EL DEBATE - 0
Profesores de nivel secundario y universitario cuentan que cambiaron sus formas de evaluar porque cada vez más alumnos les entregan textos hechos por inteligencia...
Tecnología
Cuáles son las profesiones que están en peligro por el avance de la IA, según Microsoft
Redactor EL DEBATE - 0
Mientras la inteligencia artificial gana terreno, muchas profesiones enfrentan un futuro incierto. Un estudio señala las más vulnerables… y cuáles parecen a salvo.
La inteligencia artificial (IA)...
Tecnología
IA con ritmo propio: las webs que están revolucionando la forma de hacer música
Redactor EL DEBATE - 0
Desde composiciones originales hasta letras y voces, estas herramientas con inteligencia artificial están cambiando las reglas del juego para músicos, curiosos y creativos digitales.
¿Te...